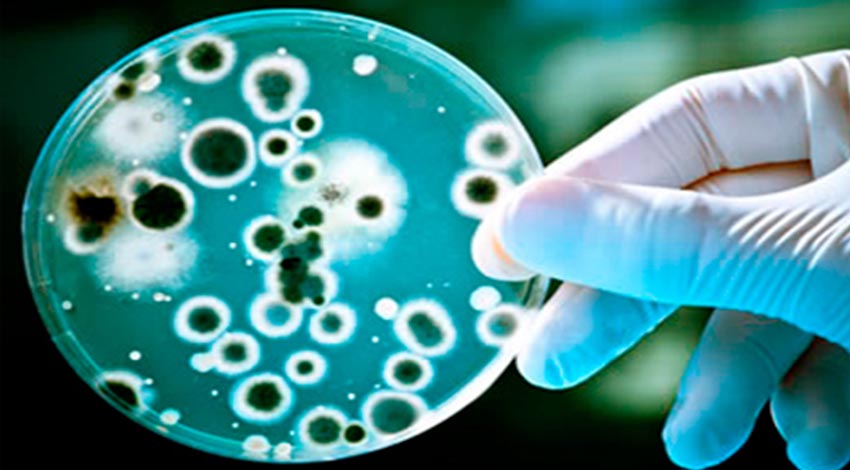

ANÁLISE DE AR CLIMATIZADO ARTIFICIALMENTE

ANÁLISE DE ÁGUA
Análise de água - consumo humano e água industrial

ANÁLISE MICROBIOLÓGICA DO AR CONDICIONADO

ANÁLISE DE LEGIONELLA SP
NOSSOS PROFISSIONAIS SÃO QUALIFICADOS PARA ATENDER AS NECESSIDADES DE CADA CLIENTE
